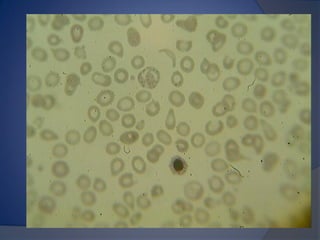
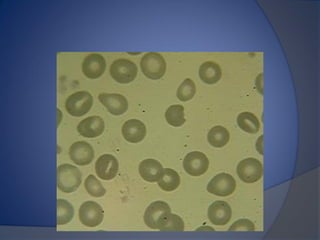
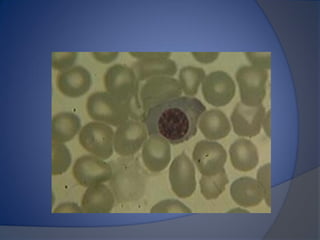
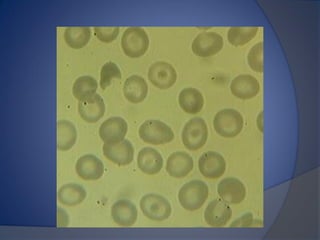
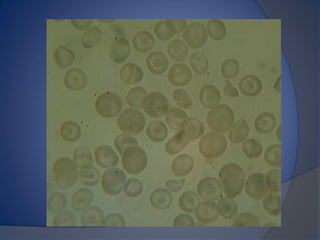
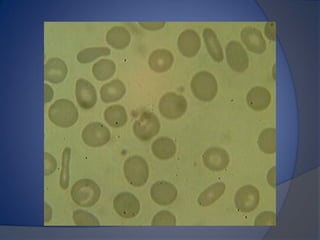
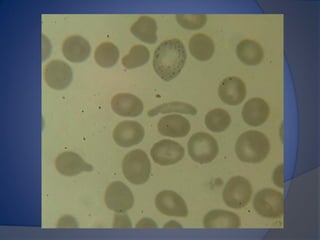
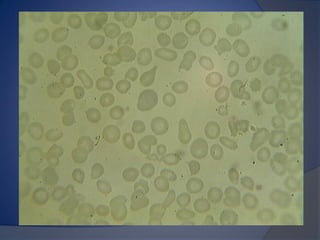
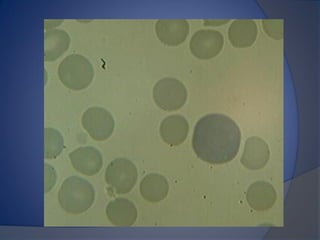
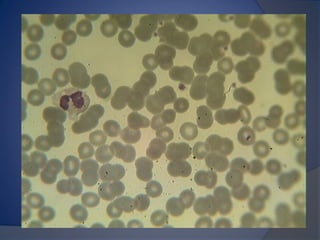
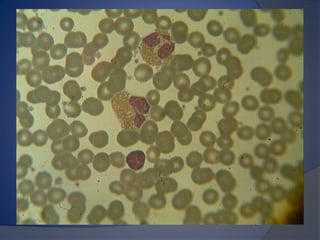

Este documento describe la biometría hemática, que consiste en un análisis cuantitativo y cualitativo de las células de la sangre. Explica que mide la fórmula roja, blanca y plaquetas, y describe los tipos de células como eritrocitos, leucocitos y plaquetas, así como sus funciones y causas de variaciones. También explica el principio de conteo celular por impedancia eléctrica y proporciona valores de referencia para la interpretación de los resultados.